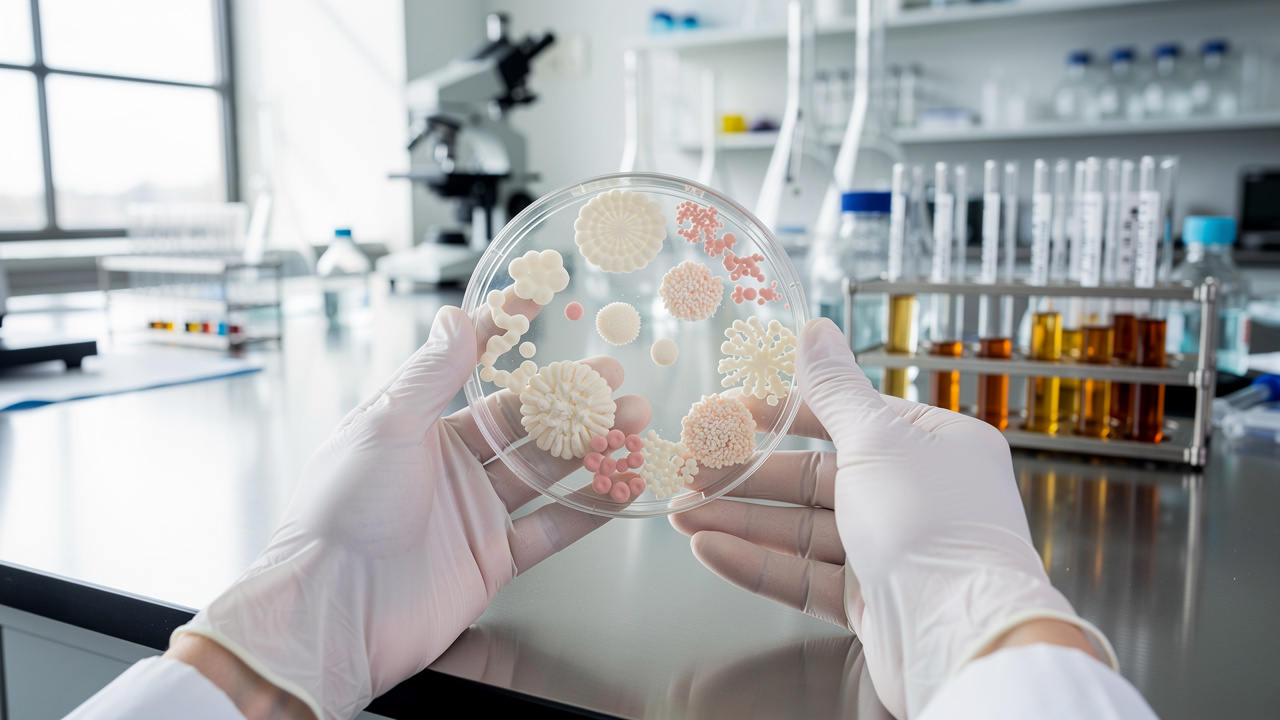
Laboratory research on beneficial gut bacteria and microbiome health

OEA Supplement For Weight Loss: Discover Its Appetite-Suppressing Benefits
Oleoylethanolamide (OEA) has moved from a relatively obscure lab compound to a serious contender for people looking for a non-stimulant, science-backed edge in fat loss. For biohackers, high-performing professionals, and athletes who want better body composition without relying on caffeine-heavy stacks, an OEA supplement for weight loss offers a compelling mix of appetite control, fat metabolism support, and metabolic health benefits.
Used well, OEA is not a magic pill, but it can make staying in a calorie deficit feel more manageable and less mentally draining.
This guide breaks down how OEA works, what the clinical data actually show, how to stack it with other compounds like berberine with ceylon cinnamon, vitamin B12, and Lion’s Mane, and how to use it intelligently inside a structured training and nutrition plan.
What Is OEA And Why Is It Used As A Weight Loss Supplement?

Oleoylethanolamide (OEA) is an endogenous fatty acid amide—your body makes it naturally. It is synthesized mainly in the small intestine from oleic acid (the primary fat in olive oil) whenever you eat dietary fat. Smaller amounts are also produced in adipose tissue and the nervous system.
Despite looking similar to endocannabinoids like anandamide, OEA does not activate CB1 or CB2 cannabinoid receptors. That means no psychotropic effects and no “munchies” problem. Instead, OEA acts through other receptors—especially PPAR‑α (peroxisome proliferator‑activated receptor alpha)—to:
-
Signal fullness after meals
-
Promote fat burning over fat storage
-
Support energy regulation and metabolic health
There is a small amount of OEA in foods such as oats, nuts, and cocoa, but typical dietary levels (often less than 2 micrograms per gram of food) are far below the doses used in human trials. That’s why people interested in body recomposition and metabolic health often turn to an OEA supplement for weight loss rather than relying on food sources alone.
How OEA Helps With Fat Loss: Core Mechanisms
The appeal of an OEA supplement for weight loss comes from the fact that it addresses several factors at once: satiety, fat metabolism, inflammation, and even the gut microbiome—mechanisms similar to those explored in research on Flexible Tactile Sensing Systems: how biological signals translate into practical metabolic outcomes.
1. PPAR-α Activation: Turning Up Fat Burning

OEA is a high‑affinity activator of PPAR‑α, a nuclear receptor expressed in tissues with high fatty acid turnover (liver, heart, skeletal muscle, brown fat).
When OEA activates PPAR‑α, it:
-
Increases expression of genes involved in fatty acid transport and β‑oxidation
-
Supports lipolysis, the breakdown of stored triglycerides into usable fuel
-
May support mitochondrial biogenesis and thermogenesis through uncoupling proteins (UCPs)
In practical terms, regular use of an OEA supplement for weight loss helps shift the body from fat storage toward fat utilization, while encouraging a higher proportion of calories to be burned rather than stored.
2. Satiety Signaling Via The Gut–Brain Axis

OEA also acts as a powerful satiety signal:
-
After a fat-containing meal, OEA production rises in the small intestine.
-
OEA activates sensory fibers of the vagus nerve, sending a “you’ve eaten enough” signal to the hypothalamus.
-
This leads to:
-
Smaller meal size
-
Longer gaps between meals
-
Reduced urge to snack between meals
-
OEA has also been shown to stimulate GLP‑1 (glucagon‑like peptide‑1) secretion from intestinal L‑cells. GLP‑1 helps:
-
Support insulin secretion in a glucose‑dependent way
-
Slow gastric emptying
-
Increase feelings of fullness
For someone using an OEA supplement for weight loss, this translates into naturally smaller portions and fewer cravings, without the wired feeling that comes from stimulant-based appetite suppressants.
3. Additional Receptor Targets: GPR119 And TRPV1
Beyond PPAR‑α, OEA interacts with:
-
GPR119, a receptor involved in glucose regulation and incretin release
-
TRPV1, a receptor tied to energy balance and thermogenesis
These interactions add another layer of support for appetite control, fat metabolism, and glycemic regulation.
What The Human Studies Show: Weight, Fat, And Metabolic Markers

OEA is not just mechanistically interesting; multiple randomized controlled trials and meta-analyses in humans support its use for body weight and metabolic health.
“What gets measured gets managed.” — Peter Drucker
Tracking body weight, waist circumference, and blood markers is especially helpful when introducing a compound like OEA.
Effects On Weight And Body Composition
Across studies, supplementation with OEA (typically 125–600 mg/day) has produced:
-
Reduced body weight and BMI
-
Meta-analyses find significant drops in both weight and BMI, especially at ≥250 mg/day and at intervention lengths of 8 weeks or longer.
-
-
Smaller waist circumference
-
OEA consistently lowers waist circumference, a proxy for visceral fat around abdominal organs.
-
-
Lower fat mass and body fat percentage
-
Trials report meaningful reductions in total fat mass and percentage body fat.
-
-
Preserved lean mass
-
OEA does not significantly reduce fat‑free mass in studies. The weight lost is predominantly fat, which helps protect metabolic rate and performance.
-
A representative trial in obese adults using 250 mg/day of OEA for 8 weeks showed significant reductions in:
-
Body weight
-
BMI
-
Waist circumference
-
Fat mass
Participants also reported less hunger and earlier fullness, consistent with OEA’s gut–brain signaling role.
Effects On Glycemic Control And Lipids
An OEA supplement for weight loss often brings measurable improvements in metabolic markers:
-
Fasting blood glucose: Reduced, particularly at doses ≥250 mg/day
-
Fasting insulin: Decreased, reflecting better insulin sensitivity
-
HOMA‑IR: Lower scores, indicating reduced insulin resistance
-
Triglycerides: Significantly reduced across studies
Total cholesterol, LDL‑C, and HDL‑C have not consistently changed in trials, but the combination of lower triglycerides, less visceral fat, and better insulin sensitivity already represents a substantial cardiometabolic upgrade.
Anti‑Inflammatory And Antioxidant Effects
Obesity and central adiposity are tightly linked to chronic low‑grade inflammation and oxidative stress. OEA addresses both:
-
Inflammation
-
Reduced C‑reactive protein (CRP)
-
Reduced TNF‑α (tumor necrosis factor‑alpha)
-
Mixed results on IL‑6, with some trials showing decreases
-
Likely mechanisms include PPAR‑α activation and inhibition of the NF‑κB inflammatory pathway
-
-
Oxidative stress
-
Lower malondialdehyde (MDA), a marker of lipid peroxidation
-
Higher total antioxidant capacity (TAC)
-
Upregulation of endogenous antioxidant enzymes (e.g., SOD, catalase, glutathione peroxidase)
-
Interestingly, some anti‑inflammatory and antioxidant benefits are pronounced even at doses below 250 mg/day, especially in women.
Gut Microbiome And Liver Health
Preclinical work adds another angle:
-
OEA increases levels of Akkermansia muciniphila, a bacterium associated with:
-
Better insulin sensitivity
-
Improved gut barrier integrity
-
Lower inflammation and healthier body composition
-
-
In animal models, OEA:
-
Reduces liver fat accumulation
-
Improves hepatic mitochondrial function and lipid metabolism
-
May help protect against fatty liver changes associated with obesity
-
For biohackers looking at the gut–brain–metabolism axis, this makes an OEA supplement for weight loss particularly interesting as part of a broader protocol.
How To Use An OEA Supplement For Weight Loss
Evidence-Based Dosage And Timing
Human trials provide a reasonable starting framework:
-
Typical effective range: 125–600 mg/day
-
Common research dose: 250 mg/day, often split into two 125 mg doses
-
Timing: About 30 minutes before meals (often lunch and dinner) to mirror natural pre‑meal signaling and support satiety during eating
-
Duration: At least 8 weeks to see reliable changes in body weight, BMI, and inflammatory markers
For most adults:
-
Start with 125–250 mg/day, taken 30 minutes before your largest meal.
-
If tolerated and under professional guidance, consider titrating toward 250 mg/day in divided doses.
Safety, Side Effects, And Who Should Be Cautious
Clinical trials show that OEA is generally well-tolerated:
-
Most common side effects (when they occur):
-
Mild GI discomfort or nausea
-
Occasional headache or transient fatigue
-
Because OEA does not bind CB1 receptors and is not a stimulant, it avoids the psychotropic and jittery side effects associated with many appetite suppressants.
People who should seek medical guidance before using an OEA supplement for weight loss include:
-
Anyone with significant gastrointestinal or metabolic disease
-
People on glucose‑lowering or lipid‑lowering medications
-
Pregnant or breastfeeding individuals
-
Those already on complex supplement stacks or IV therapy protocols (NAD+, peptides, etc.)
Stacking OEA With Other High-Impact Compounds
For performance‑oriented readers and biohackers, OEA rarely exists in isolation. It’s often combined with other ingredients to support metabolic control, cognitive performance, and sustained energy.
1. OEA + Berberine With Ceylon Cinnamon: Metabolic Stack
Berberine supports AMPK activation, insulin sensitivity, and glucose disposal. Ceylon cinnamon adds complementary support for glycemic control.
Pairing OEA with a product such as berberine with ceylon cinnamon can:
-
Improve glycemic regulation beyond either compound alone
-
Help flatten post‑meal glucose excursions
-
Support triglyceride reduction and improved lipid handling
This stack is especially attractive for:
-
People with high‑carbohydrate or mixed diets
-
Those with stubborn central adiposity
-
Individuals watching A1c, fasting insulin, or HOMA‑IR trends over time
You can also place OEA and berberine with ceylon cinnamon into the same broader metabolic protocol that may already include NAD+ IV therapy or oral NAD+ precursors, tying together mitochondrial support and appetite regulation.
2. OEA + Vitamin B12: Energy And Adherence
Caloric restriction, intense training, and heavy work demands can leave people feeling drained. Vitamin B12 supports:
-
Red blood cell formation
-
Neurological function
-
Cellular energy production
Combining an OEA supplement for weight loss with targeted energy support from vitamin B12 helps:
-
Maintain day‑long mental clarity despite lower caloric intake
-
Reduce fatigue that might otherwise lead to overeating
-
Support adherence to training and nutrition programs
This pairing suits:
-
Busy professionals in deficit who still need sharp focus
-
Endurance and strength athletes managing weight classes or cutting phases
3. OEA + Lion’s Mane And Cordyceps: Focus, Mood, And Resilience
Medicinal mushrooms bring a cognitive and stress‑resilience angle that complements appetite control:
-
Lion’s Mane: Supports nerve growth factor (NGF), cognitive performance, and mood
-
Cordyceps: Traditionally used for stamina and oxygen utilization
Blends such as mushroom cocoa with Lion’s Mane and Cordyceps or mushroom cocoa blends with Lion’s Mane and Cordyceps can:
-
Support focus and decision-making around food
-
Reduce stress‑driven, reward‑seeking eating
-
Improve perceived energy without heavy stimulants
When OEA keeps hunger in check and these mushrooms support cognition and emotional stability, the entire weight‑management strategy becomes easier to sustain, especially under work or training stress.
Integrating OEA Into Nutrition, Training, And Recovery
An OEA supplement for weight loss works best inside a coherent lifestyle framework, not as a stand‑alone fix.
“You can’t out-train a poor diet.” This common coaching line applies just as much when you add OEA—its job is to make a solid nutrition plan easier to follow, not to replace it.
Nutrition: Make Satiety Work For You
OEA amplifies the satiety impact of a smart diet. To get the most from it:
-
Prioritize lean protein at each meal (0.7–1.0 g per pound of body weight per day for active individuals).
-
Use healthy fats (olive oil, avocado, nuts) to support natural OEA production in the gut.
-
Choose high‑fiber carbohydrates (vegetables, berries, legumes, whole grains) to further support fullness and glycemic control.
-
Avoid grazing; aim for structured meals so OEA’s meal‑spacing effect can show up.
Training: Preserve Lean Mass, Support Fat Loss
Because OEA‑linked weight loss tends to spare lean mass, it pairs well with serious training:
-
Resistance training (3–5x/week) to maintain or increase muscle and resting metabolic rate.
-
Zone 2 cardio and/or intervals to improve mitochondrial function and fat oxidation.
-
Consider mushroom cocoa with Lion’s Mane and Cordyceps pre‑workout for steady energy and mental focus, while OEA helps with appetite later in the day.
Recovery, Sleep, And Stress
Chronic sleep debt and stress trigger appetite hormones and push people toward hyper‑palatable foods. To protect your investment in OEA:
-
Aim for 7–9 hours of sleep with consistent timing.
-
Use mind‑body practices (breathwork, short meditation, walking) to keep cortisol in check.
-
Lion’s Mane and other medicinal mushrooms can support mood and cognitive resilience, which indirectly stabilize eating behavior.
How To Choose A High-Quality OEA Supplement
For health‑conscious consumers and longevity‑focused athletes, product quality is non‑negotiable. When you evaluate an OEA supplement for weight loss, especially considering that dietary supplements are regulated by the Food and Drug Administration under different standards than pharmaceuticals, look for:
-
Clinical‑range dosage
-
Clearly labeled OEA content, ideally around 125–250 mg per serving
-
-
Purity and sourcing
-
Minimal excipients
-
No unnecessary fillers or artificial dyes
-
-
Third‑party testing
-
Certificates of analysis (COAs) for identity, purity, heavy metals, and microbial contamination
-
-
Transparent labeling
-
Clear indication when OEA is paired with other actives (berberine, cinnamon, vitamins, medicinal mushrooms)
-
-
Delivery form that fits your routine
-
Capsules for precise dosing before meals
-
Powders or functional drinks (such as mushroom cocoa with Lion’s Mane and Cordyceps) if you prefer stackable beverages
-
Choosing products from companies that focus on metabolic health, medicinal mushrooms, and rigorous testing helps make sure you get the intended benefits with fewer unknowns.
Limitations, Open Questions, And Future Directions
While data on OEA are promising, there are reasonable caveats:
-
Many clinical trials have been conducted in a relatively narrow geographic region; more population variety is needed.
-
Study durations are often limited to a few months; long‑term safety and efficacy still require more research.
-
Not every study shows large weight‑loss effects; outcomes depend on baseline diet, activity level, and adherence.
-
The interaction of OEA with complex stacks (peptides, NAD+ IV protocols, GLP‑1 agonists) has not been systematically studied.
Future work will likely clarify:
-
The most effective dose ranges for different goals (fat loss vs inflammatory control vs glycemic support)
-
How OEA interacts with gut microbiome‑targeted strategies, including Akkermansia muciniphila–focused interventions
-
Whether certain genotypes or phenotypes respond more strongly to OEA supplementation
For now, the existing evidence supports OEA as a meaningful adjunct to diet, training, and broader metabolic programs.
Is An OEA Supplement For Weight Loss Right For You?
If you are:
-
A biohacker or longevity enthusiast looking for a non‑stimulant way to improve appetite control and fat metabolism
-
A busy professional who needs stable energy and focus without loading up on caffeine
-
A fitness enthusiast or athlete trying to drop fat while preserving lean mass and performance
-
Someone already exploring NAD+ therapy or advanced metabolic protocols and wanting an evidence‑based appetite tool
…then an OEA supplement for weight loss is worth a serious look.
It:
-
Acts through well‑defined mechanisms (PPAR‑α, GLP‑1, vagus nerve signaling)
-
Has human data showing improvements in weight, waist circumference, fat mass, triglycerides, and insulin sensitivity
-
Helps control appetite without stimulating the central nervous system
As with any powerful tool, context matters. The best results come when OEA is paired with:
-
A structured nutrition plan
-
Consistent resistance and cardio training
-
Adequate sleep and stress management
-
Thoughtful stacking with compounds such as berberine with ceylon cinnamon, energy support vitamin B12, Lion’s Mane, and Cordyceps
Before starting, discuss OEA with a qualified healthcare professional, especially if you have existing medical conditions or use prescription medications. Used intelligently, an OEA supplement for weight loss can be a valuable part of an evidence‑driven strategy for better body composition and metabolic health.




Leave a comment
All comments are moderated before being published.
This site is protected by hCaptcha and the hCaptcha Privacy Policy and Terms of Service apply.